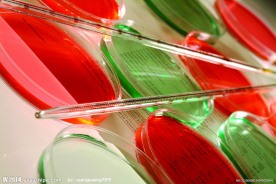
实验器皿

动漫动画
文化艺术
标志图标
底纹边框
3D设计
人物图库
自然景观
生物世界
生活百科
现代科技
商务金融
环境设计
广告设计
其他
摄影模板
PSD分层素材
web界面设计
移动界面设计
淘宝界面设计
◆
◆
-
 实验研究图像 共享分:5
实验研究图像 共享分:5 -
 实验研究图像 共享分:5
实验研究图像 共享分:5 -
 人参药酒 共享分:40
人参药酒 共享分:40 -
 鸡蛋测量 共享分:40
鸡蛋测量 共享分:40 -
 蕃茄实验 共享分:40
蕃茄实验 共享分:40 -
 实验器皿 共享分:40
实验器皿 共享分:40 -
 枸杞实验 共享分:40
枸杞实验 共享分:40 -
 小白鼠与器皿 共享分:40
小白鼠与器皿 共享分:40 -
 试管采样 共享分:40
试管采样 共享分:40 -
 洋葱精华 共享分:40
洋葱精华 共享分:40 -
 试管采样测量 共享分:40
试管采样测量 共享分:40 -
 医疗实验 共享分:40
医疗实验 共享分:40 -
 玫瑰精油 共享分:40
玫瑰精油 共享分:40 -
 灵芝精华 共享分:40
灵芝精华 共享分:40 -
 试管实验 共享分:40
试管实验 共享分:40 -
 科学研究 共享分:40
科学研究 共享分:40 -
 水果增产 共享分:40
水果增产 共享分:40 -
 种子发芽 共享分:40
种子发芽 共享分:40 -
 种子挑选 共享分:40
种子挑选 共享分:40 -
 验血化验 共享分:40
验血化验 共享分:40 -
 试管采样 共享分:40
试管采样 共享分:40 -
 鲜花实验 共享分:40
鲜花实验 共享分:40 -
 银杏精华 共享分:40
银杏精华 共享分:40 -
 植物标本 共享分:40
植物标本 共享分:40 -
 大蒜 共享分:40
大蒜 共享分:40 -
 试管采样 共享分:40
试管采样 共享分:40 -
 植物栽培 共享分:40
植物栽培 共享分:40 -
 无土栽培 共享分:40
无土栽培 共享分:40 -
 种子实验 共享分:40
种子实验 共享分:40 -
 青椒实验 共享分:40
青椒实验 共享分:40 -
 种子发芽 共享分:40
种子发芽 共享分:40 -
下一页
>>